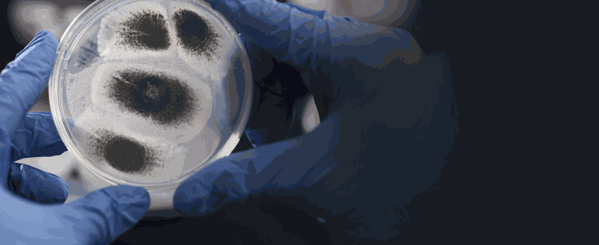

慕恩加盟
项目咨询热线
020-31603387
慕恩企业信息:
| 品牌名称 | 慕恩 | 全国门店数 | 386家 |
| 注册资本 | 100万人民币 | 成立日期 | |
| 登记状态 | 存续 | 公司类型 | 私有 |
| 所属省份 | 广东 | 所属城市 | 广州市 |
| 所属公司 | 慕恩(广州)生物科技有限公司 | 官网网址 | |
| 公司地址 | 广东省广州市黄埔区科学城开源大道11号B5栋3层 | ||
| 经营范围 | 吊顶 | ||
慕恩品牌介绍:
慕恩生物是国内专注于将微生物资源商业化的创新型生物技术公司,荣获国家高新技术企业称号,拥有国际领先的微生物组发掘和产业化平台。
公司致力于通过国际先进的微生物分离和培养技术,以发现、保存、鉴定新的具有开发价值的微生物多样性资源,建立的菌种资源库目前已收集并保存了超14万株功能菌株。在深度的微生物组研究和数据挖掘的基础上,针对急切和关键的社会市场需求(生物医药、生物农业)高通量筛选具有生物活性的功能微生物及其代谢产物,与合作伙伴携手为客户提供一流的微生物产品及其解决方案。

慕恩生物的核心团队由一批来自于中国科学院、北京大学、中山大学、台湾大学、长庚大学、德国维尔茨堡大学、荷兰皇家科学院、昆士兰大学等国内外顶级名校的博士和跨国公司的核心研发人员组成,具有独立完整的研发能力和丰富的产业化经历。
慕恩生物建立的Culture-to-Product平台,从微生物资源多样性挖掘,到活性筛选、应用测试、剂型开发和工业化生产都拥有技术优势。我们致力于为客户开发和提供专业的微生物产品及其解决方案。

我们通过国际先进的微生物分离和培养技术,发现、鉴定并保存具有开发价值的微生物多样性资源。建立的菌种资源库目前已经从农业土壤、水体、植物和人体中采集、鉴定并保存了超140000株菌株,其中拥有9000余株高价值菌株,2000多株菌株为国内甚至国际上首次发现的新物种,并且菌株数量在持续、快速地增加中。

慕恩医药核心
从无限肠道菌群到精准微生物导向药物
人体微生物组是人体健康与疾病治疗的关键枢纽,蕴含了无限枢纽靶向性药物开发宝藏。慕恩生物作为专注于创新微生态药物的生物医药公司,通过所建立的Culture-to-Product微生物组药物开发平台,系统化与精准性地找出疾病与健康枢纽靶向的活菌药物,并利用所积累的大量新基因、代谢物和信号分子的突破性认识,形成了全谱化治疗发展计划。
慕恩活菌药物
活菌药物(LBPs)是一种规范的、新兴的和革命性的新型药物,它改变了人类疾病的治疗方式。利用慕恩特有的技术平台,我们重新定义了“慕恩活菌药物”,可以精准靶向于微生物群、肠道、代谢和免疫之间相互连接的中心枢纽。慕恩活菌药物治疗方式的优点在于其高度的安全性、稳健成药性、药物联用性、快速推进临床等特点,这也赋予了慕恩进入临床阶段生物医药公司的重要核心,可以满足各种疾病治疗的需求。
吊顶品牌排行榜
吊顶热点资讯
- 友邦吊顶加盟连锁店投资要多少钱?小本投资23.2万即可
- 雅巢吊顶加盟费具体要多少?加管理费仅需7190元
- 万家乐集成吊顶加盟费多不多?保证金22570元即可加盟
- 新天地装饰公司加盟费需要是多少?加盟费只需12830元
- 先超集成吊顶加盟费得多少钱?加盟费12990元即可
- 现代吊顶加盟费需要多少?加盟费只要12870元
- 现代集成吊顶加盟要多少加盟费?保证金15470元即可
- 喜临门吊顶加盟费多少?小本投资仅需缴纳1230元使用费
- 万宝集成吊顶加盟费需要多少?加盟费只需8460元
- 西铝天花集成吊顶需要多少加盟费?加盟费至少10480元
- 西蒙幕墙吊顶板加盟费要多少钱?最低10280元轻松加盟
- 松下集成吊顶浴霸加盟费要多少?还需缴纳4260元使用费




























